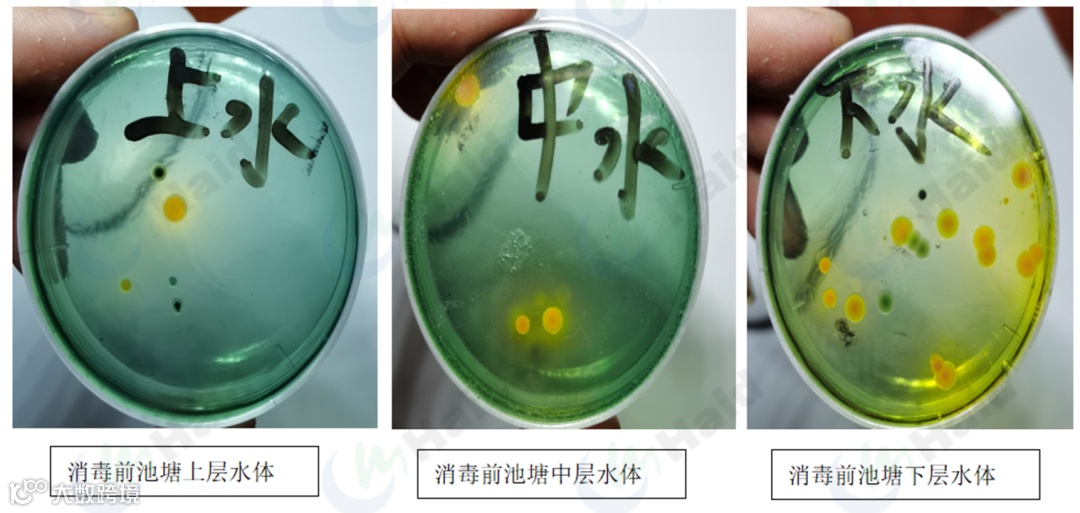
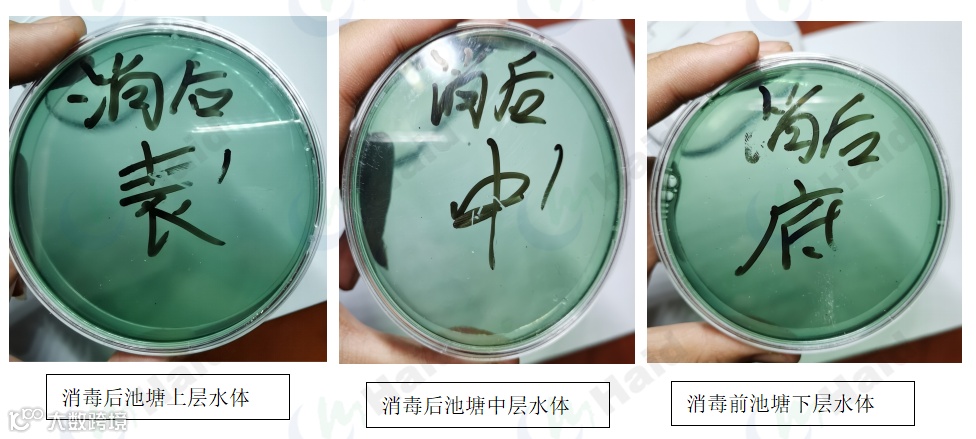
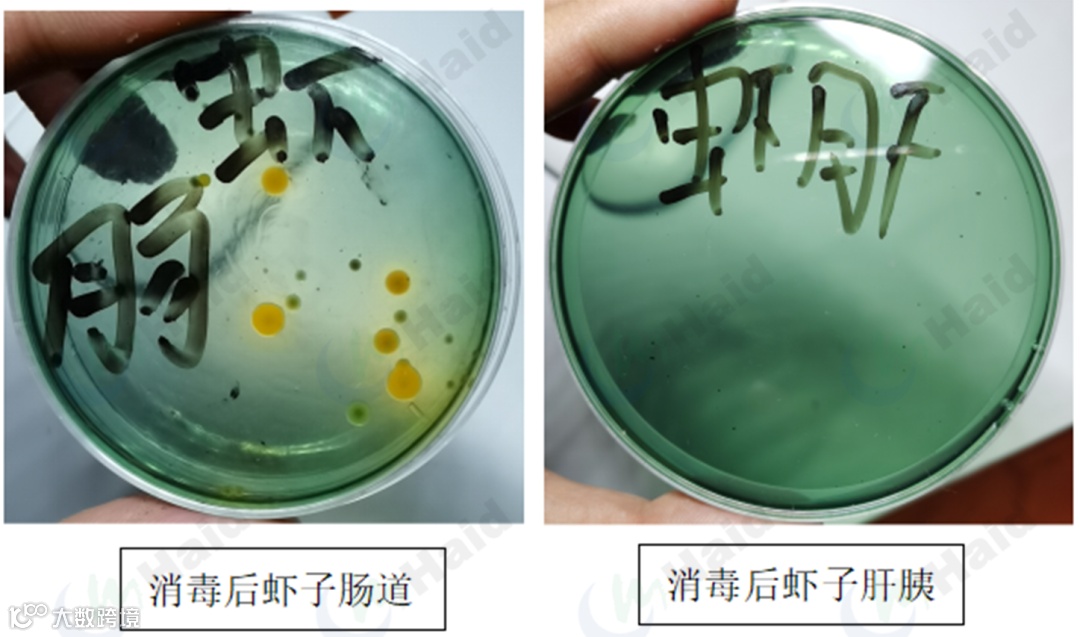

文 | 图 动保事业部 陈济丰
“养虾不瘟,富得发昏”,“谈瘟色变”等等,都是小龙虾养殖人的真实心态写照。让我们养虾人对龙虾是又爱又恨。那么,为什么小龙虾会爆发“5月瘟”呢?我们该如何预防呢?
一、“五月瘟”龙虾发病症状
如果你的塘口已经发生了龙虾爬坡上草、虾子尾部出现水泡、肝胰腺发白,头胸甲内有积液,那么就要注意了。这些都是“五月瘟”的前兆,处理不当,后续可能会带来巨大的经济损失。

左图:龙虾爬坡上草 右图:尾部出现水泡

左图:肝脏发白 右图:头胸甲内有积液
二、“五月瘟”发生的原因
1、密度原因
龙虾生长快,小虾3-5天蜕一次壳,大虾7-10天蜕一次壳,导致存塘量快速增加。存塘量的提高易导致水浑、自相残杀、溶氧不足等情况发生。
今年由于受到虾苗行情的影响,很多养殖户的虾苗销售不理想,导致今年龙虾的存塘量要远远的高于同期,龙虾密度越大,对于环境的要求就越高,因此发病的风险也就越大。所以今年龙虾的发病大概率的一定会比往年更为严重,一定要格外重视。
2、池塘环境
A、水草:水草过稀小龙虾没有隐蔽场所,导致不易蜕壳,多动、自相残杀现象的发生,易发生机体损伤。而水草疯长过密,则会大量耗氧,影响投喂与起捕。
B、水质:水过清,产生的溶氧不能满足高密度养殖要求。水过肥,影响水草活力,夜间易缺氧。水浑浊,水草脏,长势差,产氧低,病菌多。
C、底质:随着温度的升高,青苔和稻杆在池塘中腐败发酵,大量消耗溶氧,滋生病菌,败坏水质和底质;另外在投喂量加大后,残饵粪便在底部不断积累,这就为病菌的繁殖提供了大量的有利条件,威胁虾子生存。

3、气候原因
江淮地区5、6月份,气候闷热阴雨,易导致虾塘泛底,底部有害物质释放到水体中导致水质不稳,溶氧不足,病原滋生。同时天气变化剧烈,早晚温差大,易造成龙虾应激,抵抗力下降,龙虾更容易被细菌和病毒感染。

三、以防代治,破解“五月瘟”
对于小龙虾养殖来说,防控大于治疗,所以“五月瘟”问题一定要从预防做起!
1、控制密度
快速出虾,保持合适密度,不同的池塘水体生态环境和增氧配置不同,龙虾的最大存塘量是不同的,所以及时出虾,保持较低存塘量(200-250斤比较合适),有利于池塘环境的稳定,减少发病率。
2、杀菌消毒调环境
病毒和弧菌是造成五月瘟的主要原因,因此一定要做好池塘的杀菌消毒工作。

(1)使用好易典之前不同水层弧菌情况
(2)使用好易典对水体进行立体消毒

(3)使用好易典之后不同水层弧菌情况
好易典可以有效减少池塘水体中弧菌数量
(4)使用好易典之前塘里龙虾体内弧菌情况

发病龙虾体内弧菌:肠道>头胸甲积液>肝胰腺>尾部水泡
(5)使用好易典之后塘里龙虾体内弧菌情况
消毒后的池塘正常的虾子,尾部没有水泡,头胸甲无积液,虾肠道中弧菌数量明显减少,虾子肝脏中已经没有弧菌。因此好易典减少水体里弧菌的同时,还可以有效控制虾子体内弧菌。
3、做好抗应激工作
外调环境:在变天之前池塘泼洒应激灵和钙粒士,保持水体环境稳定。

内调体质:小龙虾的肝胰腺和肠道是小龙虾重要的消化和免疫系统,是免疫力的第一道防线,在5-6月份的病害高发期,饲料中拌喂虾多宝或直接投喂功能保健饲料,可以增强小龙虾的免疫力,抵抗病菌侵袭。

左图:投喂普通料的小龙虾肝胰腺
右图:投喂功能保健料的小龙虾肝胰腺
海大农牧
接地气的水产一线技术
长摁二维码,即刻关注

